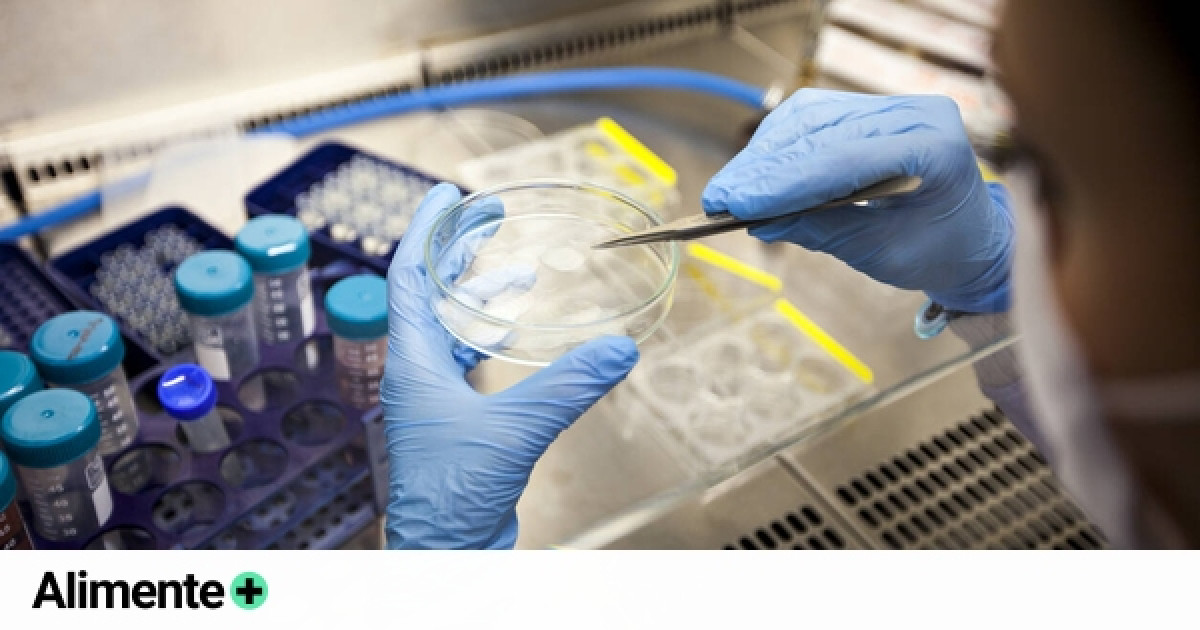
EMA recomienda autorizar en UE primera terapia de edición genética

EMA recomienda autorizar en UE primera terapia de edición genética
Por: Staff NotiGape
15/12/2023 04:50
La Agencia Europea de Medicamentos (EMA) recomendó conceder una licencia europea condicional para Casgevy, un fármaco de terapia avanzada para la anemia de células falciformes y la beta talasemia.
Este sería el primer tratamiento disponible basado en una tecnología de edición genética.
Los expertos de la EMA, han emitido una opinión positiva sobre los beneficios del fármaco destinado a contrarrestar los efectos de estos dos trastornos genéticos y, de dar la Comisión europea su visto bueno.
Casgevy sería el primer tratamiento disponible que utiliza CRISPR/Cas9, un tipo de tecnología novedosa de edición del genoma.



